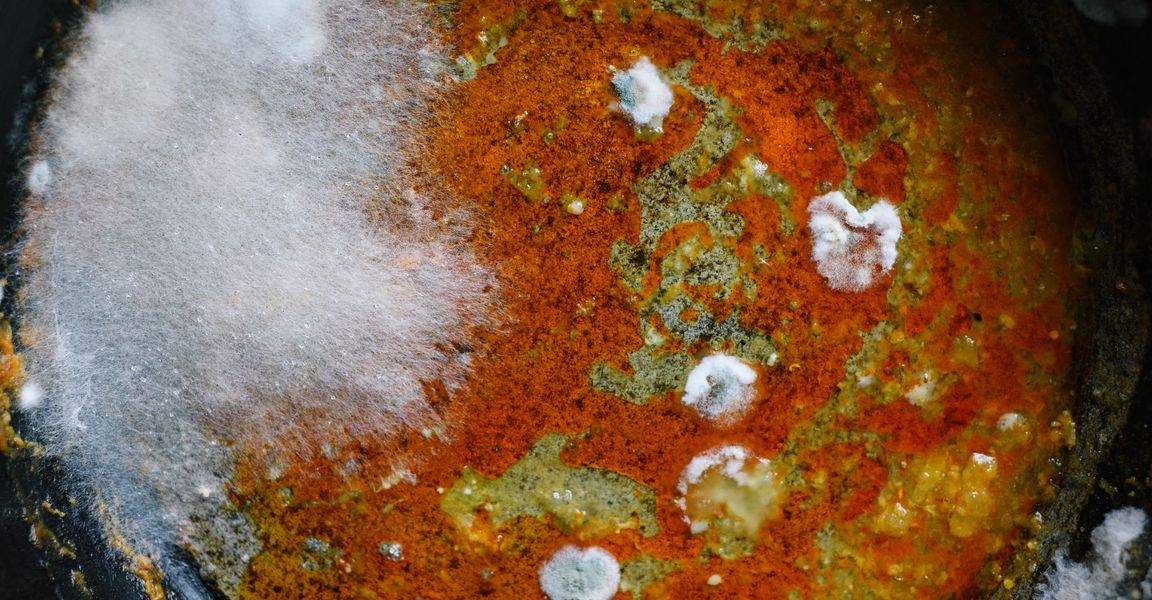

Blog Posts
Blog
Commercial Catastrophes: How Our Rapid Response Saves Your Business Revenue
In the fast-paced world of business, every minute of downtime translates directly into lost revenue and potentially damaged reputations. When a crisis strikes, the speed of your recovery is the only thing standing between a temporary setback and a permanent closure. At Triton Renovation, we specialize in managing commercial disaster recovery with a focus on speed, efficiency, and quality. We offer Real Solutions in Real Time, ensuring that your operations are back online as quickly as possible. As a premier commercial restoration company, we provide nationwide services, meaning no matter where your facility is located, our elite teams are ready to mobilize. Contact us today.
moreUnderstanding the Common Causes of Water Damage in Commercial Properties
Understanding the common causes of water damage is essential for protecting your investment and ensuring business continuity. At Triton Renovation, we know that when a crisis hits, you need more than just a contractor; you need a partner. As a leading commercial restoration company, we provide nationwide services to handle any scale of destruction. We offer Real Solutions in Real Time, ensuring that your property is stabilized and restored before further issues like mold or structural decay take hold. Contact us today.
moreWhat to Expect During the Commercial Hurricane Restoration Process
If you’ve recently experienced the devastating impact of a major storm, you know that the hours following the event are critical for your business’s survival. When you partner with Triton Renovation, you aren’t just hiring a contractor; you are securing a partner dedicated to getting your doors back open. We offer Real Solutions in Real Time, ensuring that your path to recovery begins the moment the winds die down. Here is what you can expect during the commercial hurricane restoration services process. Contact us today.
moreHow Commercial Hurricane Restoration Services Adapt to Evolving Building Codes
In the wake of a major hurricane, the structural integrity of your business is measured against more than just the elements—it must also withstand the scrutiny of updated safety standards. At Triton Renovation, we understand that rebuilding is an opportunity to fortify your property against future threats. As a leading hurricane restoration company, we ensure your facility doesn't just recover but evolves to meet the most rigorous modern demands. Here is how we adapt to evolving building codes to protect your investment. Contact us today.
moreNavigating the Insurance Maze: How Our PM Works with Adjusters
Disaster strikes when you least expect it. Whether it is a burst pipe in a high-rise or fire damage in a retail space, the road to recovery often feels like a complex labyrinth. At Triton Renovation, we understand that your priority is getting back to business. As a premier commercial restoration company, we don’t just fix buildings; we manage the entire recovery process. We offer Real Solutions in Real Time to ensure your business restoration is handled with precision. Here is how our Project Managers (PMs) work with insurance adjusters to advocate for you. Contact us today.
moreThe Importance of Detailed Documentation in Commercial Claims
When your property faces unexpected damage, the pressure to resume operations is immense. Whether you are managing an office restoration or a complex apartment restoration, the success of your recovery depends on more than just physical repairs. At Triton Renovation, we know that the backbone of a successful commercial claim is meticulous, detailed documentation. As a premier commercial restoration company, we provide Real Solutions in Real Time, ensuring that every facet of your loss is recorded to protect your bottom line. Contact us today.
moreDocument Recovery: Saving Your Hard Assets from Water and Fire
At Triton Renovation, we know that when disaster strikes your commercial property, it isn’t just the structure at risk—it’s your legacy. Whether it is a burst pipe in an office or a localized fire in a multifamily complex, your vital records, blueprints, and historical documents are often caught in the crossfire. As a leading commercial restoration company, we understand that physical assets represent years of hard work. That is why we provide specialized document recovery services designed to rescue your most sensitive information from the brink of destruction. When you face a crisis, you need a partner that provides Real Solutions in Real Time. Here is how we protect your hard assets. Contact us today.
moreCatastrophic Loss Recovery: Restoring Your Business After a Flood
The sound of rushing water is the last thing any business owner wants to hear. When a flood strikes, the clock starts ticking immediately, and the future of your operations hangs in the balance. At Triton Renovation, we understand that loss recovery isn’t just about drying floors—it’s about protecting your livelihood.
As a premier commercial restoration company, we provide the expertise needed to navigate the chaos of a disaster. Here is how you can effectively manage the journey from standing water to grand reopening. Contact us today.
moreCommercial Mold Remediation: Protecting Your Employees' Health
Managing a business means your building is more than just real estate—it is an environment where your team spends the majority of their day. Discovering mold is more than a structural nuisance; it is a direct threat to the safety of your staff. At Triton Renovation, a premier commercial restoration company, we believe that addressing mold is not just about cleaning surfaces—it is about restoring peace of mind. Contact us today.
moreGas vs. Diesel: Choosing the Right Emergency Generator for Your Commercial Building
Powering your recovery after a disaster requires more than just a quick fix; it requires a strategic choice between gas and diesel emergency generators. As a premier commercial restoration company, Triton Renovation knows that selecting the right power source is a critical decision for your facility's long-term resilience. Contact us today.
moreWhy Every Commercial Facility Needs a Generator
Running a business means being ready for the unexpected. When the power goes out, the clock starts ticking on your revenue, your safety, and your reputation. At Triton Renovation, we’ve seen firsthand how a lack of preparation can turn a minor outage into a major business restoration nightmare. As a premier commercial restoration company, we believe every facility should be equipped to stay powered up when the grid goes down. Here is why your facility needs a backup plan. Contact us today.
moreSpecialized Cleaning for Healthcare Facilities Post-Disaster
Healthcare building restoration demands a level of precision that goes far beyond standard janitorial work. When a medical facility faces a crisis, the priority is a rapid, sterile recovery to ensure patient safety and regulatory compliance. At Triton Renovation, we operate as a specialized commercial restoration company that understands the unique clinical stakes involved in getting your doors back open. Contact us today.
moreBiohazard Cleanup: Why Professional Intervention is Non-Negotiable
A biohazard situation in your facility—whether it’s a medical emergency, a sewage backup, or a traumatic incident—triggers an instinct to "just clean it up" that can be incredibly dangerous. At Triton Renovation, we know that biohazard cleanups are not standard janitorial tasks; they are high-stakes operations requiring specialized training and industrial equipment. As a premier commercial restoration company, we ensure your property is not just visually clean, but biologically safe. Professional intervention is non-negotiable for your facility for three critical reasons. Contact us today.
moreTemporary Fencing: The Second Line of Defense in Site Security
When a fire, storm, or vehicle impact compromises your facility, your immediate focus is naturally on the visible damage. Most property owners are familiar with emergency board-ups as the primary way to seal broken windows and doors, effectively closing the "gaps" in the building’s shell. However, at Triton Renovation, we’ve seen that true site integrity requires a more comprehensive, layered strategy. While boarding up secures the building envelope, temporary fencing serves as your vital second line of defense. It ensures that your entire perimeter—not just the building itself—remains untouchable during the complex recovery process.
As a premier commercial restoration company, we believe your site security should be as professional and resilient as the brand you’ve built. Because we offer nationwide services with turnkey solutions, we handle every logistical detail so you don't have to. Here is why temporary fencing is a non-negotiable component of successful business restoration. Contact us today.
moreHow Board-Up Services Protect Your Liability After a Fire
After the sirens fade and the fire department clears the scene, you are left with more than just a damaged building; you are left with a massive legal and financial liability. An open structure is an invitation for secondary disasters, and as a business owner, the burden of protection falls squarely on your shoulders. Engaging a professional commercial restoration company such as Triton Renovation for emergency board-ups is the most critical step you can take to "stop the bleed" and protect your bottom line. Here is how securing your property protects you. Contact us today.
moreStorm Prep 101: Pre-Emptive Board-Ups for High-Wind Events
High-wind events demand immediate action to protect your property and your bottom line. For many business owners, the difference between a quick recovery and a total shutdown depends on what happens before the first gust hits. Pre-emptive emergency board-ups are your first line of defense, transforming a vulnerable facility into a reinforced fortress.
As a leading commercial restoration company, we here at Triton Renovation have seen how shattering glass leads to more than just a mess—it often causes internal pressure shifts that can compromise your entire roof and structure. Contact us today.
moreThe Single Point of Contact: Why Project Management Is the Heart of Restoration
Disaster strikes your property, and the chaos can feel overwhelming. Whether it’s water damage, fire, or mold, the path to recovery involves a dizzying array of technicians, adjusters, and paperwork. This is why project management isn't just a luxury—it is the pulse of any successful commercial restoration.
At our commercial restoration company, Triton Renovation, we believe you shouldn't have to play "telephone" between five different contractors while trying to keep your business afloat. By providing a single point of contact, we transform a fragmented process into a streamlined recovery. Contact us today.
moreThe Lifecycle of a Commercial Roof: What to Expect at Years 5, 15, and 25
Maintaining a commercial property is a marathon, not a sprint. Your roof is the first line of defense against the elements, but its needs change significantly as it ages. Understanding the transition from a new installation to an aging asset helps you budget effectively and avoid the sudden crises that interrupt your operations.
Whether you are managing a warehouse, retail space, or office complex, here is what you can expect at the key milestones of your roof’s life from Triton Renovation. Contact us today.
moreFire and Smoke: Why the Smell Lingers and How We Neutralize It
After the flames are extinguished, a new battle begins for business owners: the persistent, pungent smell of smoke. At Triton Renovation, we know that a lingering odor is more than just an inconvenience—it is a reminder of a traumatic event that can deter customers and impact employee morale. Understanding why that smell stays and how to professionally remove it is the first step toward recovery. Contact us today.
moreThe Art of the Pack-Out: How We Inventory and Protect Your Business Assets
Disaster doesn't just threaten the four walls of your building; it puts your entire operational inventory at risk. At Triton Renovation, we understand that your equipment, furniture, and records are the heartbeat of your organization. As a premier commercial restoration company, we’ve mastered the "Art of the Pack-Out"—a specialized process designed to inventory, clean, and store your assets with military precision. Contact us today.
moreInsurance Consulting: Why You Need a Restoration Partner, Not Just a Contractor
When disaster strikes your commercial property, the clock starts ticking immediately. Whether you are dealing with office restoration after a burst pipe or complex apartment restoration following a fire, the gap between "getting it fixed" and "getting it right" often comes down to one thing: insurance consulting.
At Triton Renovation, we know that a standard contractor focuses on the hammer and nails, but a true partner focuses on your recovery. As a premier commercial restoration company, we don’t just rebuild; we advocate. Contact us today.
moreSpeaking "Adjuster": How Triton Renovation Bridges the Gap Between Business Owners and Insurance
Disaster strikes your commercial property, and suddenly you aren’t just dealing with physical damage—you’re thrust into a complex world of specialized jargon and high-stakes negotiation. To a property owner, a "loss" is a devastating interruption; to an insurance company, it is a technical data point. This language barrier often leads to delays and undervalued claims. As a premier commercial restoration company, Triton Renovation serves as your expert translator and advocate through professional insurance consulting. Contact us today.
moreBeyond the Naked Eye: Using Thermal Imaging to Find Hidden Water Intrusion
Hidden moisture is a silent threat to any commercial property. After a leak or storm, water often seeps deep into structural components, hiding behind drywall or beneath flooring. This leads to mold growth and structural decay long before a visible stain ever appears. At Triton Renovation, a premier commercial restoration company, we believe that what you cannot see can still damage your bottom line. We utilize advanced thermal imaging services to detect hidden water intrusion with surgical precision. Contact us today.
moreTemporary Roofing: Keeping Your Business Dry While Awaiting Permanent Repairs
When a disaster strikes your commercial property, the clock starts ticking. Whether it is a severe storm, fire, or unexpected structural failure, your priority is to minimize downtime and prevent further loss. At Triton Renovation, we understand that permanent repairs can take time to coordinate with adjusters and engineers. That is why we provide high-quality temporary roofing as a critical first step in the commercial restoration process.
As a leading commercial restoration company, we offer Real Solutions in Real Time to ensure your assets remain protected from the elements. Contact us today.
moreVandalism and Break-ins: How Rapid Boarding Prevents Secondary Loss
Discovering that your property has been a target of vandalism or a break-in is a distressing experience for any owner or manager. Beyond the initial shock and the immediate loss of assets, the clock begins ticking on "secondary loss"—damage that occurs after the initial event due to exposure or lack of security. At Triton Renovation, we understand that your priority is securing your investment and returning to business as usual. As a premier commercial restoration company, we offer nationwide services to ensure that no matter where you are, you have access to professional commercial restoration. Contact us today.
moreSecuring the Perimeter: The Importance of Professional Emergency Board-Ups
When disaster strikes your property—whether it’s a break-in, a severe storm, or an unexpected fire—the immediate aftermath is often chaotic. Your priority shifts from daily operations to one critical goal: securing the perimeter. At Triton Renovation, we understand that every minute your building remains exposed is a minute you are vulnerable to theft, vandalism, and further weather damage.
As a premier commercial restoration company, we don't just fix buildings; we protect your livelihood. Here is why professional board-up services are a non-negotiable first step in your recovery.
moreThe Science of Structural Integrity: How Triton Renovation Identifies Hidden Failures After a Storm
When a major storm hits, the immediate damage—shattered windows or flooded lobbies—is often all you see. However, at Triton Renovation, we know that what lies beneath the surface is what truly determines the safety of your property. As a premier commercial restoration company, we specialize in uncovering the "invisible" consequences of extreme weather to ensure your building remains sound for years to come. Contact us today.
moreOverhaul Rehabilitations: When a "Patch Job" Isn’t Enough
Maintaining a commercial property is a constant balancing act between budget and quality. When you notice a leak in the roof or a crack in the foundation, the instinct is often to look for the quickest fix. However, there comes a point where a simple "patch job" is no longer a viable strategy for your business restoration. At Triton Renovation, we specialize in overhaul rehabilitation—a deep-dive approach that secures your investment for the long haul. Contact us today.
moreFlat Roofs 101: Understanding Your Repair and Replacement Options
When you manage a commercial property, the roof above your head is more than just a structure—it is a critical asset that protects your inventory, equipment, and people. Flat roofs are the standard for most industrial and commercial buildings due to their space efficiency and cost-effectiveness, but they come with unique maintenance challenges. As a premier commercial restoration company, Triton Renovation understands that a "one size fits all" approach doesn’t work for complex roofing systems. Whether you are dealing with a sudden leak or planning for a long-term upgrade, understanding your repair and replacement options is the first step toward protecting your investment. Contact us today.
moreThe Top 6 Signs Your Commercial Roof is Failing (and How to Catch Them)
As a business owner, your facility is one of your most significant investments. Whether you manage a sprawling warehouse or a high-traffic retail space, the roof over your head is the primary line of defense against the elements. However, roof issues are often "out of sight, out of mind" until they cause a major disruption.
At Triton Renovation, we’ve seen how minor issues can spiral into a full-blown crisis. Understanding the warning signs of a failing roof can save you from a complete shutdown and thousands in structural repairs. As a premier commercial restoration company, we are here to help you identify these red flags early. Here are the top six signs your commercial roof is failing and how you can catch them before they escalate. Contact us today.
moreThe Overhaul Playbook: How We Transform an Aging Apartment Complex (While Minimizing Tenant Disruption)
As your trusted commercial restoration services provider with nationwide coverage, Triton Renovation ensures that your asset receives superior value enhancement while we minimize inconvenience to the people who call your property home. Contact us today.
moreWhy One Call is Better Than Three: The Benefit of a Single Partner for Roofing, Painting, and Structural Repair
At Triton Renovation, we understand that time is money, and efficiency is key. Instead of coordinating three different companies for your structural, painting, and roofing needs, you gain a massive advantage by choosing one cohesive partner. As your single, expert provider, we deliver streamlined service for all aspects of your building’s exterior, offering nationwide services to ensure consistency and quality, no matter where your properties are located. Contact us today.
moreBudgeting for a Full Building Overhaul: What Property Managers Need to Know
As a property manager facing a full building overhaul, you know that budgeting is the critical foundation for success. A renovation of this scale is a complex undertaking, and a partnership with an expert commercial painting contractor like Triton Renovation, who offers nationwide services, is key to managing costs and ensuring value. We specialize in comprehensive commercial restoration services, helping you navigate these major projects efficiently. Contact us today.
moreMore Than Just Curb Appeal: How Protective Coatings Safeguard Your Commercial Building
At Triton Renovation, we view these coatings as an essential element of your asset protection strategy, going far beyond a fresh coat of paint to fortify your structure. Contact us today.
moreThe Hidden Dangers: Why You Can't Ignore Crumbling Concrete on Your Commercial Building
The appearance of cracking, chipping, or commercial spalling repair issues on your building’s concrete surfaces isn't just an eyesore—it's a flashing red warning sign. Ignoring these seemingly minor flaws can lead to catastrophic damage, regulatory fines, and significant financial liability. Delaying action will only allow the damage to compound, turning a manageable commercial concrete repair issue into a massive, costly overhaul. Learn more from Trition Renovation below, and contact us today.
moreWhat is Concrete Spalling? A Simple Guide for Property Managers
As a property manager, maintaining the structural integrity and aesthetic appeal of your assets is crucial. One of the most common and damaging issues you'll encounter is concrete spalling, often described as the flaking, chipping, or pitting of the concrete surface. Ignoring it can lead to extensive and costly commercial structural repair down the line, compromising the safety and value of your commercial buildings. Understanding the causes and repair methods is the first step toward effective property stewardship. Learn more from Trition Renovation below, and contact us today.
moreThe ROI of a Fresh Exterior: How Repainting Your Commercial Property Increases its Value
As a commercial property owner or manager, you know every investment must deliver a return. A fading, peeling, or outdated exterior doesn't just look tired—it actively depreciates your asset. Investing in professional commercial exterior painting is not just an aesthetic upgrade; it’s one of the most cost-effective ways to ensure a high Return on Investment (ROI) for your commercial building painting project. Triton Renovation offers nationwide commercial coating services designed to maximize your property's value. Contact us today.
moreFaded, Peeling, or Chalking? 6 Signs Your Commercial Building is Crying for a New Coat
As a property manager or building owner, you look at your asset every single day. It’s easy to think of your building's paint as purely cosmetic—a color choice that impacts curb appeal. But the truth is, that "paint" is a high-performance protective coating. It’s your building's primary line of defense against water, UV radiation, and wear. When that defense fails, it's not just an aesthetic problem; it's a direct threat to your asset's structural integrity.
At Triton Renovation, we are a premier commercial painting contractor, and we know that a failing coat is a clear cry for help. Here are the six signs you need to look for. Contact us today.
moreFrom Cracked to Secure: How Structural Repair Protects Your Tenants and Your Asset
As a building owner or facility manager, you walk your property every day. You notice the small things, such as a crack. That crack is a warning sign. It’s a symptom of a deeper, more destructive problem that, if ignored, can compromise the safety of your tenants and the structural integrity of your entire asset. That crack is a clear and present danger and a sign you need professional commercial structural repair.
At Triton Renovation, we believe in stopping small problems from becoming catastrophic failures. Here’s our guide to understanding the true risk of damaged concrete and the critical importance of timely repairs. Contact us today.
moreThe Facility Manager's Guide to TPO Roofing Systems
In the complex world of commercial roofing, facility managers have many options, but one system has consistently risen as a top choice for modern buildings: TPO (Thermoplastic Olefin). It’s a smart, efficient, and durable solution. But what really makes it stand out, and is it the right choice for your property? As a leading commercial restoration contractor with nationwide experience, we at Triton Renovation want to give you the complete guide to TPO roofing systems. Contact us today.
moreIntegrating Modern, Energy-Efficient Materials into Your Commercial Renovation
When planning a renovation, it’s easy to focus on aesthetics. But a truly smart renovation looks deeper, seizing the opportunity to build long-term value and efficiency into your property. Integrating modern, energy-efficient materials can dramatically lower your operating costs and create a more comfortable, sustainable environment. At Triton Renovation, we believe a renovation should prepare your building for the future. Here are three key areas to focus on for maximum impact. Contact us today.
moreFlood Damage vs. Water Damage: Understanding the Difference for Your Insurance Claim
When your commercial property is sitting in water, your first thought is "damage." But in the world of insurance, the source of that water is everything. You might use the terms "flood damage" and "water damage" interchangeably, but to your insurance carrier, they are completely different events with different policies. Understanding this distinction is the first and most critical step to a successful claim. Here’s what you need to know from Triton Renovation. Contact us today.
moreThe Benefits of a Proactive Commercial Roofing Maintenance Plan
As a property or facility manager, you view your building as a major investment. But how much thought do you give to its most critical protector—the roof? Waiting for a leak to appear is a reactive strategy that often leads to expensive, large-scale problems. A proactive commercial roofing maintenance plan, however, protects your asset, your budget, and your peace of mind. Here are three key benefits of working with a professional restoration company from Triton Renovation. Contact us today.
moreWhen to Call a Mold Professional: A Guide for Facility and Property Managers
You walk into a basement, storage room, or vacant unit and immediately notice it: that distinct, musty odor. It’s easy to dismiss it as an "old building smell," but you shouldn't. That smell is often the first and most obvious sign of a hidden moisture problem and an active mold colony. Here are three critical reasons from Triton Renovation why you must take that smell seriously. Contact us today.
moreIs That "Musty Smell" in Your Commercial Building a Sign of a Major Mold Problem?
You walk into a basement, storage room, or vacant unit and immediately notice it: that distinct, musty odor. It’s easy to dismiss it as an "old building smell," but you shouldn't. That smell is often the first and most obvious sign of a hidden moisture problem and an active mold colony. Here are three critical reasons from Triton Renovation why you must take that smell seriously. Contact us today.
moreThe Clock is Ticking: Why You Shouldn't Wait to File a Hail Damage Insurance Claim
After a severe hailstorm, your focus is on cleanup. But the costliest mistake you can make is delaying your insurance claim. The clock starts ticking the moment the hail stops, and waiting can jeopardize your claim and lead to escalating problems. When it comes to hail storm damage, procrastination is a financial disaster. At Triton Renovation, we urge property owners to act fast. Here are three critical reasons why you shouldn't wait to file your claim from Triton Renovation. Contact us today.
moreA Property Manager's Guide to Performing a Post-Hailstorm Roof Inspection
As a property manager, you know hailstorms pose a serious threat to your assets. After a storm passes, a prompt inspection is crucial to prevent minor issues from becoming major expenses. While some damage is obvious, much of it can be hidden from plain sight. At Triton Renovation, we know quick action is key to properly assessing hail storm damage. Contact us today.
moreThe Silent Threat: Unseen Health Risks of Mold in a Commercial Building
When you spot a dark patch creeping up a wall or catch a musty odor in the air, your first thought might be about property damage. While mold certainly compromises the structural integrity of your building, its most dangerous threat is often invisible. The silent spread of mold spores can create significant health risks for your employees, tenants, and customers, turning your property into a source of illness. As a leading nationwide commercial restoration company, Triton Renovation knows that what you can't see can indeed hurt you. Here are six health risks associated with mold in a commercial building that you cannot afford to ignore. Contact us today.
moreOur 24/7 Emergency Restoration Services: A Step-by-Step Look at What Happens When You Call
Disasters don't clock out at 5 PM. A burst pipe at midnight, a fire alarm blaring on a holiday, or a storm tearing through your property – these emergencies can strike at any moment, threatening your assets and disrupting your life. When the unexpected happens, you need a reliable partner who understands the urgency and has the expertise to act fast. That's where Triton Renovation comes in. As a leading commercial restoration company serving nationwide, we offer 24/7 emergency restoration services, ensuring that when you call, we're already moving to provide turn-key solutions. But what exactly happens when you reach out in a crisis? Let’s take a step-by-step look. Contact us today.
moreNot Just Dents: The Hidden Structural Dangers of Hail Damage to Your Commercial Roof
After a severe hailstorm passes, it’s a common relief to look at your commercial roof and see what appears to be only minor, cosmetic denting. Many property managers might dismiss this as insignificant, but this is a critical mistake. The visible dents are rarely the real threat. The true danger of hail lies in the hidden, long-term structural damage that can compromise your entire building envelope, leading to the need for extensive hail damage restoration.
At Triton Renovation, we want to educate building owners on what our experts look for after a storm. Understanding these hidden dangers is the first step in protecting your investment. Contact us today.
moreA Seasonal Maintenance Checklist for Your Commercial Property
As a commercial property owner or manager, you know that your building is a significant investment that requires constant attention. The most effective way to protect that investment is not through reactive repairs, but through proactive, seasonal maintenance. As a provider of nationwide restoration services, we at Triton Renovation have seen how deferred maintenance can lead to catastrophic failures in all climates. This seasonal checklist is designed to help you stay ahead of the curve, protect your asset, and ensure your property remains safe and functional year-round. Contact us today.
moreThe Importance of Immediate Action After Commercial Water Damage Occurs
When water damage strikes your property, the clock starts ticking immediately. Whether it's from a burst pipe, a leaking roof, or a major flood, the initial hours are the most critical. Taking immediate action can be the difference between a manageable situation and a catastrophic loss. At Triton Renovation, we’ve seen firsthand how swift intervention can save property owners time, money, and stress. Here are five key reasons why you must act fast after water damage occurs. Contact us today.
moreCommon Myths About Water Damage Restoration Debunked
Water damage can be a devastating event for both homeowners and businesses alike. Despite the reality of water damage restoration, many myths persist that can lead to misunderstandings about the restoration process. At Triton Renovation, a leading commercial water damage restoration company offering turn-key restoration services nationwide, we are here to debunk some of the most common myths surrounding water damage. Understanding the truth can help you respond more effectively when faced with water-related issues. Contact us today.
moreThe Role of Technology in Commercial Water Damage Restoration
Water damage can be a devastating event for any commercial property, leading to extensive damage and costly repairs. The good news is that advances in technology are drastically changing the landscape of water damage restoration. At Triton Renovation, we pride ourselves on being a leading commercial water damage restoration company, offering turn-key restoration services nationwide. In this blog, we will explore the pivotal role technology plays in water damage cleanup and restoration, ensuring efficient, effective, and comprehensive recovery. Get started today.
moreHow to Create a Water Damage Emergency Response Plan for Your Business
Water damage can strike unexpectedly, wreaking havoc on your business operations and leading to extensive repair costs. Creating an emergency response plan is vital for minimizing damage and ensuring a rapid recovery. At Triton Renovation, we offer nationwide commercial restoration services with turn-key solutions to help you navigate water damage situations effectively. Here’s how to create a comprehensive water damage emergency response plan for your business. Contact us today.
moreChoosing the Right Commercial Restoration Company for Water Damage
When faced with water damage, the stakes are high for your business. Not only does water damage disrupt operations, but it can also lead to long-term issues like mold growth and structural damage. The importance of choosing the right commercial restoration company cannot be overstated. At Triton Renovation, we offer nationwide commercial restoration services with turn-key solutions tailored to your needs. Here are six essential points to consider when selecting the right team for your water damage restoration. Contact us today.
moreHow to Minimize Downtime for Your Business During Water Damage Restoration
Water damage is a serious issue for businesses, and its effects can ripple through operations, impacting everything from productivity to revenue. When faced with water damage, the clock is ticking, and every minute counts. If your business is in need of immediate assistance, reaching out to a trusted commercial water damage restoration company like Triton Renovation is key. We are here to help you understand how to minimize downtime during the water damage restoration process so you can get back to business quicker. Contact us today.
moreThe Difference Between Residential and Commercial Water Damage Restoration
When it comes to water damage restoration, understanding the differences between residential and commercial settings is essential for effective damage control and recovery. At Triton Renovation, we specialize in both residential and commercial water damage cleanup, offering nationwide coverage and turnkey solutions to meet your needs. Here’s what you need to know about the distinctions in the restoration process for homes versus commercial properties. Contact us today.
moreUnderstanding Insurance Coverage for Commercial Water Damage Claims
Navigating the complexities of insurance coverage for commercial water damage claims can be daunting. As a business owner, understanding your policy can help you prepare for unexpected events and ensure you maximize your water damage restoration efforts. At Triton Renovation, we specialize in water damage cleanup and restoration, providing nationwide coverage and turnkey solutions to get your business back on track. Here are six important points to consider when dealing with your insurance company after experiencing water damage. Contact us today.
moreKey Steps in the Commercial Water Damage Restoration Process
Experiencing water damage can be a significant setback for any business. Understanding the commercial water damage restoration process is essential to getting your operations back on track as quickly as possible. At Triton Renovation, a nationwide commercial restoration company, we specialize in handling water damage with efficiency and expertise. Here are the key steps involved in the restoration process, designed to help you mitigate losses and reclaim your space. Contact us today.
moreAssessing the Financial Impact of Water Damage on Your Business
Water damage can be devastating for any business, leading to prolonged downtime and significant financial losses. At Triton Renovation, a nationwide commercial restoration company, we understand the intricacies of water damage and its potential financial implications. Assessing the financial impact of water damage is crucial for protecting your business. Here are six key points to consider when facing water damage and the subsequent restoration process. Contact us today.
moreSigns Your Commercial Property May Have Hidden Water Damage
Identifying hidden water damage in your commercial property is crucial for maintaining a safe and functional environment. Water damage can lead to structural issues, mold growth, and other serious problems that can impact your business operations. At Triton Renovation, a nationwide commercial restoration company, we want to help you recognize the signs of hidden water damage so you can address it promptly and effectively. Here are six signs that your commercial property may have unseen water damage. Contact us today.
moreSecuring Supply Chains and Logistics During Commercial Tornado Damage Restoration
Securing supply chains and logistics during tornado damage restoration is a critical aspect of effective recovery after a devastating storm. At Triton Renovation, a nationwide commercial restoration company, we understand the challenges businesses face in restoring operations while navigating the complexities of supply chain disruptions caused by tornadoes. Here are six essential strategies to help you efficiently manage your supply chains and logistics during tornado restoration. Contact us today.
moreSmart Landscaping Practices to Minimize Tornado Damage Around Commercial Structures
Tornadoes can wreak havoc on commercial properties, leading to significant damage and costly repairs. As a proactive measure, it’s essential to implement smart landscaping practices that can minimize tornado damage and enhance the resilience of your commercial structures. Triton Renovation, a nationwide commercial restoration company, offers insights into six effective landscaping strategies that can protect your property from the destructive forces of tornadoes. Contact us today.
moreMaximizing Insurance Coverage for Commercial Tornado Damage Restoration
When a tornado strikes, the aftermath can be devastating, especially for businesses. Tornado damage restoration is not only essential for getting your operations back on track, but it can also be a complicated process involving insurance claims. At Triton Renovation, a leading nationwide commercial restoration company, we understand the nuances of insurance coverage and how to maximize it. Here are six practical tips to help you make the most of your insurance coverage during tornado damage restoration. Contact us today.
moreMost Common Damages Sustained to a Commercial Building During a Tornado
Tornadoes are nature's formidable forces, capable of inflicting substantial damage in mere moments. For business owners, understanding the potential impacts of a tornado on commercial buildings is crucial not just for preparation but also for ensuring effective tornado damage restoration after a storm. At Triton Renovation, we specialize in nationwide tornado restoration and have witnessed firsthand the various types of damage that often occur. Here are the six most common damages you may encounter in a commercial property during a tornado. Contact us today.
moreRestoring Retail Spaces for Customer Engagement After Tornado Damage
Experiencing tornado damage can be devastating for retail spaces, affecting not only the structure but also customer engagement and overall business operations. At Triton Renovation, we understand the significance of restoring your retail environment effectively, ensuring your business can reopen its doors to eager customers. Our expertise in tornado damage restoration is designed to revive your retail space and foster customer engagement. Here are six key points to consider when restoring your retail space after tornado damage. Contact us today.
moreBuilding Materials to Install to Minimize Commercial Tornado Damage
When it comes to protecting your commercial property from tornadoes, choosing the right building materials is crucial. At Triton Renovation, we understand the devastation tornadoes can inflict; that’s why we’re dedicated to providing effective tornado damage restoration services. Here are six types of building materials you should consider to minimize tornado damage, and remember—we serve nationwide. Contact us today.
moreTips for Swift Roof Repairs and Temporary Coverings to Prevent Further Damage Post-Tornado
Tornadoes can occur with little warning, causing devastating damage to commercial facilities. As a commercial property owner or manager, having a comprehensive tornado preparedness plan is crucial to safeguard your business and minimize potential loss. Here are six essential tips to help you develop an effective tornado preparedness plan, brought to you by Triton Renovation, a leading commercial restoration company specializing in tornado damage restoration. Contact us today.
moreTips for Developing a Comprehensive Tornado Preparedness Plan for Commercial Facilities
Tornadoes can occur with little warning, causing devastating damage to commercial facilities. As a commercial property owner or manager, having a comprehensive tornado preparedness plan is crucial to safeguard your business and minimize potential loss. Here are six essential tips to help you develop an effective tornado preparedness plan, brought to you by Triton Renovation, a leading commercial restoration company specializing in tornado damage restoration. Contact us today.
moreEffective Space Planning in Commercial Properties for Tornado Damage Restoration
When a tornado causes significant damage to your commercial property, effective space planning becomes crucial for a successful restoration. At Triton Renovation, we understand the challenges that come with tornado damage restoration and the importance of optimizing your space to meet your business needs. Here are six essential tips for effective space planning during the tornado restoration process. Contact us today.
moreTips to Slowly Reopen Your Business After Commercial Tornado Damage
Experiencing tornado damage can be devastating for a business, leaving physical destruction and emotional turmoil in its wake. At Triton Renovation, we understand the challenges that arise during tornado restoration and how critical it is to approach the reopening process methodically. Here are six tips to help you navigate the path to recovery and successfully reopen your business. Contact us today.
moreThe Importance of Swift Commercial Tornado Restoration
As a leader in commercial tornado restoration services, we at Triton Renovation understand the critical importance of swift response and efficient restoration processes following a devastating tornado event. Tornadoes can cause significant damage to commercial properties, leading to structural issues, water damage, and other related challenges that can impact business operations and occupant safety. In this article, we will explore the importance of swift commercial tornado restoration and outline six key reasons why prompt action is essential for successful recovery. Give us a call today.
moreInnovative Tools and Techniques in Commercial Tornado Damage Restoration
As a leading commercial restoration company, Triton Renovation is dedicated to providing innovative tools and techniques in tornado damage restoration services. Our comprehensive approach to tornado restoration combines cutting-edge technologies, advanced methodologies, and expert craftsmanship to deliver top-quality restoration solutions for commercial properties nationwide. Learn more about innovative tools and techniques in commercial tornado damage restoration, and call us for a free quote today.
moreCommon Commercial Hurricane Restoration FAQs: Answering Your Burning Questions
When it comes to commercial hurricane restoration, we at Triton Renovation understand the urgency and complexity involved in the process. As a leading commercial hurricane damage restoration company, we are dedicated to providing expert services that help businesses recover swiftly and effectively. Here are answers to four common FAQs related to commercial restoration. Contact us for a free quote today.
moreWhen to Call for Emergency Board-Ups
At Triton Renovation, a nationwide commercial restoration company, we understand that emergencies can happen at any time, leaving your commercial property vulnerable and in need of immediate protection. That's why we offer emergency board-up services to secure your building and minimize further damage in the event of a disaster. Our team of experts specializes in commercial restoration and is available 24/7 to respond promptly to your emergency needs. Discover when it's crucial to call for emergency board-ups from Triton Renovation and how we can help protect your property. Contact us today.
moreRestoring Your Business's Reputation After a Hurricane With Professional Restoration Services
Hurricanes can cause severe damage to businesses, resulting in disruptions to daily operations, loss of customers, and damage to a company's reputation. However, with the help of professional restoration services from Triton Renovation, you can restore your business's reputation and get back on track.
At Triton Renovation, we understand the importance of a business's reputation and the impact it has on its success. Our team of experts specializes in commercial hurricane restoration services, and we are dedicated to helping businesses recover from the aftermath of a hurricane. Learn more below, and contact us today!
moreUnderstanding Insurance Coverage for Commercial Hurricane Restoration Services
Commercial properties are vulnerable to extensive damage during hurricane events. To protect your investment and ensure a quick recovery, it is essential to understand your insurance coverage for commercial hurricane restoration services. At Triton Renovation, we have assisted numerous businesses in navigating their insurance policies after hurricane damage. Let us guide you through the process and help you make the most of your coverage. Learn more below, and contact us today!
moreEnsuring Business Continuity: How Commercial Hurricane Restoration Services Can Help
In today's fast-paced business world, disaster preparedness is key to ensure the smooth functioning of operations. Natural disasters, such as hurricanes, are unpredictable and can cause significant damage to businesses. To mitigate the impact of such events, commercial hurricane restoration services play a crucial role. In this blog, we will explore how Triton Renovation, a nationwide commercial hurricane restoration company, can help businesses ensure continuity during and after a hurricane. Contact us today!
morePreparing Your Employees for Commercial Hurricane Restoration: What You Need to Know
Hurricanes can wreak havoc on businesses and disrupt daily operations. As a business owner, it is essential to adequately prepare your employees for the process of commercial hurricane restoration. By educating and involving your staff, you can ensure a smooth transition into the restoration phase and minimize disruption. In this blog, we will explore important steps and guidelines from Triton Renovation to help you prepare your employees for commercial hurricane restoration. Contact us today!
moreHow Commercial Hurricane Restoration Services Assist with Mold Remediation and Prevention
In the aftermath of a hurricane, the devastation left behind often goes beyond physical damage to properties. One of the most concerning issues that arise is the growth and spread of mold. Mold can cause severe health problems and damage to the affected structures if not addressed promptly and effectively. This is where commercial hurricane restoration services, like Triton Renovation, play a crucial role in assisting with mold remediation and prevention. In this blog post, we will explore the importance of these services and how they can help restore safety and stability to hurricane-affected areas.
moreThe Financial Consequences of Delaying Commercial Hurricane Restoration Services
When a commercial property is affected by a hurricane, time is of the essence when it comes to restoration. One of the most significant consequences of delaying commercial hurricane restoration services is the potential for heightened financial costs. While it may be tempting to postpone commercial hurricane restoration due to budget constraints or other reasons, the long-term financial implications can be far more detrimental. In this blog post from Triton Renovation, a top-rated commercial restoration service company, we will explore the various financial consequences that can arise from delaying commercial hurricane restoration services, emphasizing the importance of immediate action.
moreThe Environmental Impact of Commercial Hurricane Restoration Services
Commercial hurricane restoration can have a significant impact on the environment. While the immediate focus is on restoring damaged properties and communities, it is essential to consider the environmental consequences of restoration efforts. Triton Renovation, a leading nationwide commercial hurricane restoration company, recognizes the importance of sustainability and implements measures to minimize the environmental footprint of their commercial hurricane restoration services. Learn more below, and contact us today!
moreThe Role of Technology in Commercial Hurricane Restoration Services
In recent years, the increasing frequency and intensity of hurricanes have wreaked havoc on commercial properties, leaving behind a trail of destruction and requiring extensive restoration efforts. In this challenging and time-sensitive situation, technology plays a crucial role in streamlining and enhancing the commercial hurricane restoration services provided by companies like Triton Renovation. Learn more about the role of technology in commercial hurricane restoration services, and contact us today!
moreThe Unexpected Benefits of Commercial Hurricane Restoration Services
When hurricanes strike, they leave behind a trail of destruction and devastation. While the immediate focus is on the safety and recovery of individuals, restoring damaged buildings and infrastructure is also crucial. Commercial hurricane restoration services play a critical role in the recovery process, providing expertise in repairing and restoring commercial properties.
Triton Renovation, a prominent restoration service company that offers the best hurricane damage restoration services nationwide, not only helps businesses get back on their feet but also offers unexpected benefits that go beyond mere restoration. In this blog post, we will explore the unexpected benefits of our commercial hurricane restoration services. Call for a free quote today!
moreThe Role of Commercial Hurricane Restoration Services in Protecting Historic Buildings
Historic buildings are architectural treasures that not only hold significant cultural and historical value but also contribute to the identity and charm of a city. However, these structures are often vulnerable to the destructive forces of natural disasters, particularly hurricanes. As hurricanes become increasingly frequent and intense, the role of commercial hurricane restoration services becomes crucial in safeguarding and preserving these irreplaceable pieces of our heritage. In this blog post, we will explore how our commercial hurricane restoration company, Triton Renovation, and our commercial hurricane restoration services play a fundamental role in protecting historic buildings. Contact us today!
moreHow to Avoid Common Mistakes When Hiring a Commercial Flood Damage Restoration Company
Hiring the right commercial flood damage restoration company is crucial for the well-being and recovery of your business after a catastrophe. There are common mistakes that businesses often make during the hiring process, which can lead to costly consequences. By avoiding these mistakes, you can ensure the best possible restoration services for your commercial property. Triton Renovation is a leading commercial flood damage restoration company that can help your business after a flood or water disaster. Let our experienced team get your business back up and running as quickly as possible. Continue reading to learn more, and contact us for a free estimate today!
moreThe Importance of Documenting Flood Damage for Commercial Insurance Purposes
When a flood occurs at a commercial property, the damage can be catastrophic. In these unfortunate situations, properly documenting flood damage becomes crucial for insurance purposes. Commercial property owners need to provide clear and comprehensive evidence of the damage to their insurance companies to successfully file a claim and receive the appropriate compensation.
Triton Renovation offers commercial flood damage restoration services nationwide, leveraging a national network of trade professionals to ensure your commercial property is restored to its previous condition. Here are several reasons why documenting flood damage is of utmost importance for commercial insurance purposes. Contact us for a free estimate today!
moreWhat to Look for in a Commercial Flood Damage Insurance Policy
Flooding can cause devastating damage to a business, leading to significant financial losses, halted operations, and damaged property. With the increasing frequency of natural disasters, commercial flood damage insurance has become a fundamental need for any business that wants to mitigate potential losses in the event of a flood.
As a business owner, choosing the best commercial flood damage insurance policy can be challenging, particularly if you don't understand the intricacies of the policy terms. Triton Renovation offers the best commercial flood damage restoration if your business suffers flood damage. We work closely with your insurance company to ensure prompt payment, so you can get back to business. Here are some key features that you should look for when choosing commercial flood damage insurance. Contact us for a free estimate today!
moreCommon Causes of Flood Damage in Commercial Buildings
Floods can happen anytime and anywhere without warning, causing damage to commercial properties, interrupting business operations, and leading to significant financial losses. Flood damage can be disastrous for a business, leading to lost profits, damage to structural elements, and data loss. Knowing what causes flood damage to commercial buildings can help business owners mitigate the potential risk and prepare for a flood crisis.
Triton Renovation offers the best commercial flood damage restoration services for your office complex, apartment building, retail outlet, and more. Our team offers real solutions in real-time, mobilizing a national network of professionals for 24-hour emergency response services. In this article, we explore common causes of flood damage in commercial buildings. Contact us for a free estimate today!
moreThe Importance of Disaster Preparedness for Your Employees
Disaster preparedness is the process of making plans and taking necessary actions to mitigate the impact of a natural or human-made disaster. An unexpected event, such as a hurricane, earthquake, or fire, can occur at any time, and it is essential to have a plan in place to help your employees navigate through it. There are several reasons why disaster preparedness is necessary in the workplace, and in this blog, we'll discuss some of them. Triton Renovation is a top-rated commercial restoration service that offers 24-hour response times when disasters strike. Contact us for a free estimate today!
moreThe Benefits of Investing in Fire Damage Prevention for Businesses
As a business owner, protecting your business assets and employees should be a top priority. Having a comprehensive fire damage prevention plan in place is one of the best ways to protect your business. Preventing fires can save your business from the devastating effects of property damage, potential employee injuries, litigation costs, and long-term recovery times.
Triton Renovation offers wonderful and comprehensive fire damage restoration services nationwide. Our team offers a plethora of services to help your business recover in the event of a fire. Here are some of the benefits of investing in fire damage prevention for businesses. Contact us for a free estimate today!
moreFire Damage Prevention Tips for Commercial Spaces, Part 2
In part one of this blog, we discussed many common fire damage prevention tips for commercial spaces, such as installing fire suppression systems, electrical safety, the importance of fire drills, and recommending regular inspections. Triton Renovation, a leading commercial fire damage restoration specialist, recommends more tips below on how to prevent fire damage at your business. Keep reading below to learn more, and contact us for a free estimate today!
moreFire Damage Prevention Tips for Commercial Spaces, Part 1
Commercial spaces are often home to expensive equipment, important documents, and valuable inventory. Protecting these assets should be a top priority for commercial property owners. One of the most significant threats to commercial businesses is fire. Not only can fires cause significant property damage, but they can also pose a risk to employees and customers. Therefore, fire damage prevention is critical.
Triton Renovation offers the best commercial fire damage restoration services nationwide with a team of trade professionals ready to help. From condominiums and office buildings to apartment complexes and retail centers, we can help restore your property to like-new condition after a fire. Here are some tips for preventing fires in commercial spaces. Contact us for a free estimate today!
moreCommon Fire Damage Restoration Services, Part 2
In our last blog post, we discussed common fire damage restoration services for commercial properties, including emergency board up services, water removal and drying, smoke and soot removal, and contents cleaning and restoration. In this continuing blog post, we'll take a look at more of the common fire damage restoration services we offer. If you have experienced a commercial fire at your business, call Triton Renovation, a specialist in commercial fire damage restoration with more than 40 years of experience, for a free quote today!
moreCommon Fire Damage Restoration Services, Part 1
Fire is one of the most devastating disasters that can happen in a home or commercial property. The damage caused by smoke and flames can be extensive, and the restoration process can be complicated and expensive. Fortunately, there are many fire damage restoration services available to help property owners recover from the damage caused by fires. Triton Renovation is a leader in fire damage restoration services nationwide. We offer 24-hour emergency fire damage restoration, and we offer comprehensive services, from full reconstruction to emergency board-ups. Let our team restore your property to like-new condition. Contact us for a free estimate today!
moreTips for Reducing Fire Damage in Commercial Properties
Owning a commercial property can be a great investment, but it also comes with the responsibility of protecting that property from potential disasters. One of the most devastating disasters any property owner can face is a fire. Not only can fires put your tenants and employees at risk, but they can also cause extensive damage to your property and financial loss. However, by taking a few simple steps, you can reduce the risk of fire damage in your commercial property.
Should your commercial business suffer a fire, Triton Renovation is here to help. We have more than 40 years of experience helping with commercial fire damage restoration. We offer comprehensive services nationwide, as well as emergency fire damage restoration. Learn some tips for reducing fire damage in commercial properties, and contact us for a free estimate today!
moreHow to Make Sure Your Building is Properly Secured During a Flood Restoration
Floods can be catastrophic to buildings, leaving extensive damage in their wake. During a flood event, the primary concern is to ensure the safety of individuals affected by the flooding. However, once the floodwaters recede, it is necessary to restore the building to its pre-flood condition and prevent further damage. It's essential to ensure that your building has proper security measures in place during the restoration process.
Triton Renovation offers the best commercial restoration services for floods, fires, hurricanes, and other natural disasters. Our 24-hour emergency response teams are ready to help when you need us the most.Here are some tips to make sure that your building is properly secured during flood restoration. Contact us for a free estimate today!
moreThe Importance of a Generator For Your Business
A generator is an essential piece of equipment for any business. It provides a reliable source of backup power in the event of an electrical outage, storm, or natural disaster, ensuring that your business can continue to operate even if the power goes out. Having a generator also provides peace of mind in knowing that your business will be able to stay up and running, regardless of what happens.
Triton Renovation offers the best in disaster restoration services for businesses, including hurricane restoration, tornado restoration, and flood and fire restoration. Learn about the importance of having a generator for your business below, and contact us for standby generators and commercial restoration services today!
moreHidden Dangers of Residual Smoke Damage to Your Employees
When a building has experienced a fire, the damage caused by smoke can be just as dangerous as the fire itself. Not only can smoke damage your business’s building and belongings, but the residual smoke damage can cause health hazards to your employees. Triton Renovation offers comprehensive smoke damage restoration services. Learn more about the hidden dangers of residual smoke damage to your employees below, and contact us today!
moreHow to Ensure The Smoke Is Fully Remediated After a Fire
Fires can cause a lot of damage to a building and its contents. Along with the physical damage, there is the problem of smoke contamination. Smoke can travel through walls, ceilings, and other structures, leaving behind a residue that can be hazardous to your health. The longer the smoke remains in the building, the more damage it can cause. Therefore, it is important to remove the smoke and ensure that it is fully remediated after a fire. Triton Renovation has more than 40 years of smoke restoration services. Learn more about ensuring the smoke from a commercial fire is fully remediated below, and contact us today!
more4 Hidden Dangers of Flooding You May Not Know About
Flooding is one of the most destructive natural disasters, and it’s important to be aware of the dangers it can present. Many people are familiar with the immediate dangers of flooding, such as the potential of being trapped in a home or office space, having your property damaged, and the potential of being injured or even killed. But there are some hidden dangers that can come along with flooding that many people do not consider when they are preparing for and responding to a flood.
Here at Triton Renovation, we help businesses around the country recover from flood damage by offering the best flood restoration services. Learn more below, and contact us today!
moreTips for Preventing Hail and Storm Damage
Hail and storm damage can be a major headache for business owners. Damage to roofs, siding, windows, and fleet vehicles can be expensive and time-consuming to repair. Fortunately, there are things you can do to protect your business from hail and storm damage. If your business does suffer from hail and/or storm damage, call Triton Renovation, a nationwide storm restoration company, today.
more5 Things To Look For In A Commercial Restoration Company
Choosing a qualified commercial restoration company to handle your business restoration project can be a daunting task. You want to ensure you are getting the best quality service for your money and that the company you hire is experienced and reliable. Triton Renovation has been offering our best commercial restoration services for more than 40 years. Here are four things to look for when choosing a commercial restoration company, and contact us today!
more4 Common Mistakes Businesses Make During Hurricanes
Hurricanes can be a major challenge for businesses of all sizes. Whether you are located in a coastal area or an inland area, it is important to understand the potential risks associated with hurricanes and take the necessary precautions to protect your business. Triton Renovation offers hurricane restoration services nationwide. Here are four common mistakes businesses make during hurricanes. Contact us today!
moreWays to Prepare Your Business for Tornado Season
Tornado season is a dangerous time of year for businesses, as high winds and other extreme weather can wreak havoc on your property and operations. Preparation is key to ensuring that your business is ready to weather the storm of a tornado and return to normal operations as soon as possible. Triton Renovation is a leader in tornado damage restoration for businesses. Here are a few ways to prepare your business for tornado season. Contact us today!
more4 Steps To Take Immediately After Being Hit By A Tornado
Tornadoes can be an unpredictable and devastating force of nature that can cause serious damage to homes and businesses. In the blink of an eye, entire neighborhoods and businesses can be destroyed and lives can be changed forever. As such, it is important to know what to do immediately after being hit by a tornado in order to help minimize the damage to your commercial space and stay safe.
Triton Renovation is here to help. Our team of experts boasts more than 40 years of experience helping businesses that have been hit by tornadoes with their restoration needs. Here are four steps to take immediately after being hit by a tornado. Contact us today!
moreCommon Causes of Commercial Fire Damage
Commercial fires can be devastating for businesses, leading to financial loss and disruption to daily operations. Fire damage can result in the destruction of supplies, merchandise, and even the building itself. To help protect your business and property, it’s important to understand the common causes of commercial fire damage. That being said, if you do experience commercial fire damage to your building, Triton Renovation is here to help. We leverage a national network of craftsmen to respond to your emergency quickly, offering turn-key solutions that will restore your building to like-new. Learn more about the common causes of commercial fire damage below, and contact us for a free estimate today!
moreStrategies for Mitigating Further Damage During Water Restoration Projects
Commercial water restoration projects can be costly, time-consuming, and emotionally draining. If not executed properly, the damage from a water incident can be compounded and cause further disruption to your business. Thankfully, there are strategies that can be employed to ensure that further damage is mitigated during a water restoration project. Triton Renovation offers superior commercial water restoration services to restore your building to like new condition after a disaster or flood strikes. Learn more below, and contact us for a free estimate today!
moreMaking the Most of Your Commercial Water Restoration Budget
Water restoration can be a costly undertaking, but it is a necessary one if you want to protect your business from potential damage. With the right planning and budgeting, you can make the most of your water restoration budget and ensure that your office space is safe and secure. Triton Renovation offers the best in commercial water restoration services, helping you recover and restore your building when a natural disaster strikes. Learn more about how to make the most of your commercial water restoration budget, and contact us for a free estimate today!
moreThe Benefits of Professional Water Restoration Training for Property Managers
As a property manager, it is essential to have the right training to ensure that any water-related problems are dealt with in a timely and efficient manner. Professional water restoration training provides the knowledge and skills necessary to prevent and respond to water damage and restoration issues immediately, helping to limit the damage. This type of training can help property managers to better protect their assets and ensure their tenants’ safety. Triton Renovation is a leading provider of emergency commercial restoration services, including water damage restoration. Learn more below, and contact us for a free estimate today!
moreThe Role of Insurance in Covering the Cost of Commercial Water Restoration
Commercial water restoration is an essential part of keeping businesses up and running. For companies that suffer from water damage due to flooding, pipe bursts, or other disasters, insurance can play a major role in covering the costs of restoration.
Triton Renovation offers water damage restoration for commercial businesses nationwide. We respond promptly to your needs and begin the restoration process as soon as it's safe to do so, enabling you to get back to "business as usual" sooner rather than later. In this blog post, we’ll explore the role of insurance in covering the cost of commercial water restoration. Contact us for a free estimate today!
moreThe Impact of Poor Water Management on Commercial Structures
Water is essential for all living things and is a major component of our environment. Poor water management is a growing problem that can have a devastating impact on commercial structures, businesses, and the environment. It can also lead to flooding of local buildings.
Triton Renovation is a commercial restoration company that helps businesses who've suffered from water and flood damage restore their building to like-new conditions. In this blog, we'll discuss the causes of poor water management, its effects on commercial structures, and what can be done to improve water management practices. Contact us for a free estimate today!
moreWarning Signs Your Commercial Roof Isn't Safe
When it comes to your commercial roof, safety should always be a top priority. Not only does your roof protect your business from the elements, but it also serves to keep employees and customers safe from potential hazards. Unfortunately, commercial roofs can be vulnerable to wear and tear over time, leading to potential safety issues that can hurt your business in the long run.
Triton Renovation is a restoration company that offers full-scale renovation services, including roof repairs for commercial businesses. To help you identify when your commercial roof may not be safe, here are some warning signs to look out for. Contact us today!
moreCommon Storm Damage Repairs You Should Know
The damage caused by storms can range from minor inconveniences to major disasters, leaving business owners with costly repairs. Whether you’re dealing with a minor storm-induced issue or an extreme weather event, it’s important to know what storm damage repairs you should consider, and how to best protect your property. Triton Renovation is a storm damage restoration company that offers emergency response nationwide. Learn about some common commercial storm damage repairs you should know, and contact us today.
more5 Steps to Take After Storm Damage
Storms can cause significant damage to homes and property, so it’s important to know what to do after the storm has passed. Taking the right steps quickly can help you minimize further storm damage and ensure that your property is restored as quickly as possible. Here at Triton Renovation, we've seen our share of storm damage in the 40 years we've been involved in storm damage restoration for commercial businesses. Here are five steps to take after storm damage. Contact us today!
more4 Important Places to Inspect After A Fire
Fire is one of the most destructive forces on Earth. After a fire, there are several important places in your commercial business to inspect to ensure safety and prevent further damage. Triton Renovation is a leader in fire disaster response. We offer smoke and fire restoration services across the country, including emergency restoration services. Here are four important places to inspect after a fire. Connect with us today!
moreCommon Mistakes that Lead to Fires
Fires are one of the most destructive and dangerous disasters that can occur. They can cause devastating damage to property, injuries, and even death. It is important to understand the causes of fires and how to prevent them. Triton Renovation offers the best smoke and fire restoration services for commercial businesses nationwide. Learn about some of the common mistakes that can lead to fires below, and contact us today!
more4 Important Fire Prevention Tips
Fire prevention is an essential part of the safety of your business. Taking the proper steps to prevent a fire can help save lives and property. Triton Renovation offers the best commercial disaster renovation and restoration services nationwide. Here are four important fire prevention tips to keep in mind for your business, and contact us today!
moreUnderstanding the Different Types of Water Damage and How to Address Them
Water damage is an unfortunate reality of life. Whether it is caused by a natural disaster, a plumbing issue, or something as simple as a broken pipe, water damage can be devastating. It can lead to a range of problems, from property damage to health risks. Luckily, companies such as Triton Renovation, a commercial water damage restoration company, can help. We offer 24-hour response in order to get your restoration going for quicker results. Understanding the different types of water damage and how to address them is essential in preventing and resolving water damage issues. Learn more below, and contact us for a free estimate today!
moreHow to Properly Respond to a Water Damage Emergency
Responding to a water damage emergency can be a challenging and overwhelming experience. Knowing what steps to take can help minimize the damage and make sure your business is safe and secure. Triton Renovation has more than 40 years of experience of responding to emergency disasters and offering the best remediation services no matter the disaster, from hurricanes to tornadoes. Here are some tips on how to properly respond to a water damage emergency. Contact us to begin!
moreThe Benefits of Investing in Industrial-Grade Water Restoration Equipment
Investing in industrial-grade water restoration equipment can provide numerous benefits to businesses and organizations. Industrial-grade water restoration equipment can help to reduce the amount of time and money spent on water damage restoration and repairs, as well as help to increase the safety of the environment and people in the area. It is important to understand the advantages of investing in industrial-grade water restoration equipment in order to make the best decision for your business or organization.
Here at Triton Renovation, our commercial water restoration company carries the newest industrial-grade water restoration equipment for our commercial restorations. We make it a point to stay on top of the technology in order to deliver you, our customers, a superior result. Learn more about the benefits of industrial-grade water restoration equipment, and contact us today.
moreTips for Keeping Your Commercial Building Safe From Water Damage, Part 2
Keeping your commercial building safe from water damage is an important task. Water damage can be costly and cause a lot of damage that is difficult to repair. Our water restoration company, Triton Renovation, is here to help should a natural disaster cause water damage and other types of damage to your property. Here are some more tips to help keep your commercial building safe from water damage. Contact us today.
moreTips for Keeping Your Commercial Building Safe From Water Damage, Part 1
Water damage can be a huge problem for commercial buildings, resulting in costly repairs, lost time, and even health risks. Triton Renovation is a water restoration company that helps commercial businesses nationwide when a natural disaster strikes, such as a tornado, hurricane, or flood. In order to avoid water damage, it’s important to take proactive steps to protect your commercial building. Here are some tips for keeping your building safe from water damage. Call us for 24-hour emergency response today!
moreWhat Business Owners Need to Know About Professional Water Restoration Services
Water damage is a major concern for businesses, especially those that operate from a physical location. Professional water restoration services can provide the expertise and resources needed to get your business back up and running quickly and safely. In this blog, we’ll cover what business owners should know about professional water restoration services, the benefits of hiring a professional service, and how to choose the right one for your specific needs. Triton Renovation offers commercial water damage restoration services nationwide. Call today!
moreHow to Choose the Right Materials for Your Commercial Restoration Project After a Storm Hits
Choosing the right materials for a commercial restoration project is an important decision to make, especially after a destructive storm has left your business in disarray. The right materials will not only help you restore the building to its pre-storm condition, but also help ensure that it is structurally safe and secure for years to come. Triton Renovation is a nationwide commercial restoration contractor that offers restoration, remediation, and renovation. Learn more about how to choose the right materials for your commercial restoration project after a storm hits, and contact us today!
moreUnderstanding the Cost of a Restoration Project When a Storm Hits
The aftermath of a storm can be devastating for any commercial business owner. Not only can storms cause major structural damage, but they can also lead to costly restoration projects. Understanding the cost of a restoration project when a storm occurs is essential to ensure that you have the financial resources necessary to repair any damage caused. Here at Triton Renovation, we are keenly aware that the cost of a restoration project is important to you. We have optimized our renovation and restoration processes so that our commercial restoration and renovation services are affordable. Learn more about the cost of a restoration project when a storm hits below, and contact us today!
moreThe Difference Between Restoration and Renovation
When a storm occurs, it can cause a devastating amount of damage to homes and businesses. After the storm has passed, the process of restoring the property to its original condition begins. The two major categories of restoration and renovation are important to understand in order to properly address the damage and make the necessary repairs. Triton Renovation offers a plethora of storm damage restoration and renovation services, including tornado damage restoration, hurricane restoration, flood damage remediation, and more. Learn about the difference between restoration and renovation below, and contact us today!
moreChallenges of Commercial Storm Damage Restoration Projects
Commercial storm damage restoration projects can be complex endeavors that require a great deal of skill and expertise to successfully complete. From coordinating with insurance companies and local authorities to dealing with hazardous materials and taking on the risk of working in hazardous environments, there are a number of unique challenges that must be taken into account. With our four decades of experience, Triton Renovation offers exceptional commercial restoration and remediation after a storm hits. In this blog, we will discuss some of the common challenges associated with commercial storm damage restoration projects and how to overcome them. Contact us today!
moreCommon Commercial Building Restoration Problems and Solutions
Commercial building remediation is a process of repairing, restoring, or cleaning up a building to make it safe, secure, and healthy after a disaster strikes. It can involve a variety of activities such as the removal of hazardous materials, decontamination, and repairs of structural damage caused by natural disasters, fire, or other sources. Remediation is an important step in keeping commercial buildings safe and functional for both occupants and visitors. Triton Renovation offers 24-hour response to your commercial restoration needs after a disaster strikes. With more than 40 years of experience, we can help. There are a number of common problems that arise during commercial building remediation. Contact us to get started today!
moreWelcome
Welcome to our site! We are in the process of building our blog page and will have many interesting articles to share in the coming months. Please stay tuned to this page for information to come. And if you have any questions about our business or want to reach out to us, we would love for you to stop by our contact page.
Thank you!
more